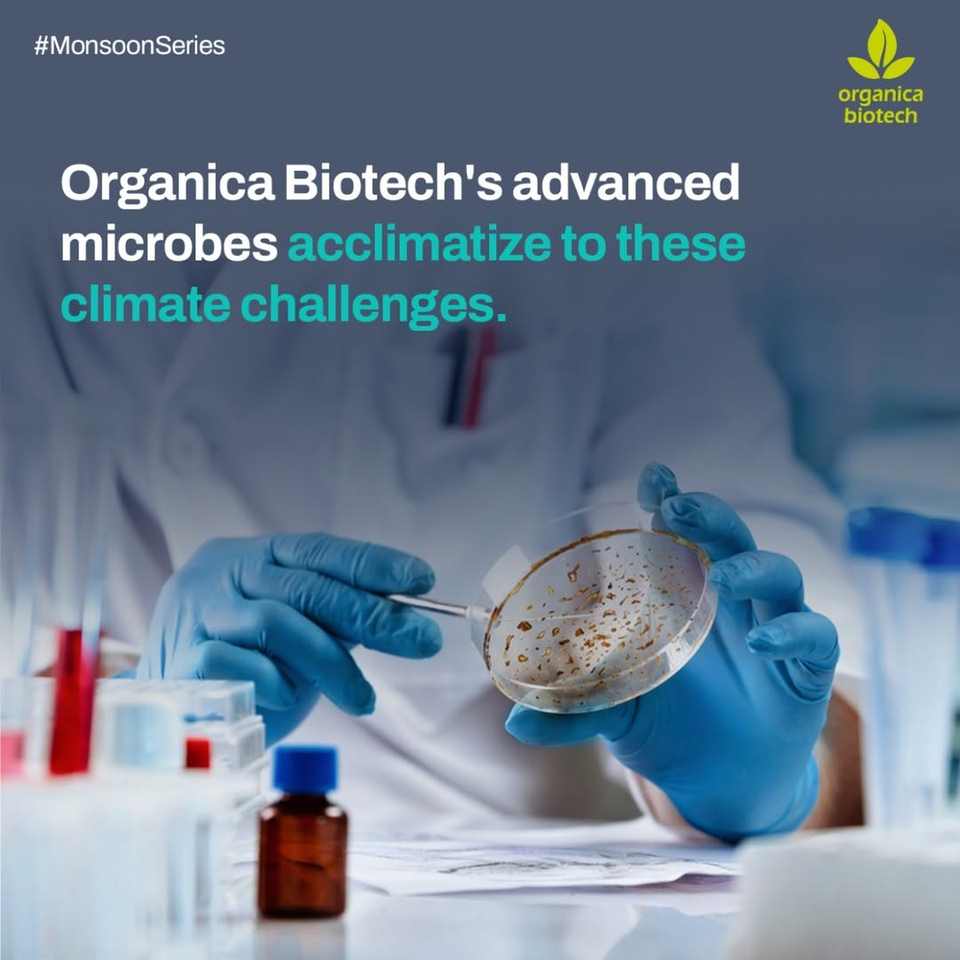

บำบัดน้ำเสียจากโรงสีข้าว
ยังไม่มีรีวิว

คุณลักษณะ
ไขมัน, น้ำมัน, น้ำยาล้างกลิ่นประเภทการประมวลผล
500L/ชั่วโมงผลผลิต
ดีโฟมเมอร์Core ส่วนประกอบ
800Wพลังงาน (W)
110Vแรงดันไฟฟ้า
2 ปีการประกัน
เครื่องจักร Test Report:ให้บริการโดย
วิดีโอขาออก-ตรวจสอบ:ให้บริการโดย
น้ำหนัก (กก.):1
สถานที่กำเนิด:Maharashtra, India
ชื่อแบรนด์:Bioclean
ฟังก์ชัน:เพิ่มอิมัลซิไฟเออร์และการทำให้เป็นไมโครของสารประกอบไฮโดรคาร์บอน
คุณสมบัติ:การเพิ่มตะกอนและการเกิดฟองในถังชีวภาพ
คุณสมบัติที่สำคัญ
ประเภทการประมวลผล
ไขมัน, น้ำมัน, น้ำยาล้างกลิ่น
ผลผลิต
500L/ชั่วโมง
Core ส่วนประกอบ
ดีโฟมเมอร์
พลังงาน (W)
800W(1.07hp)
แรงดันไฟฟ้า
110V
การประกัน
2 ปี
เครื่องจักร Test Report
ให้บริการโดย
วิดีโอขาออก-ตรวจสอบ
ให้บริการโดย
น้ำหนัก (กก.)
1
สถานที่กำเนิด
Maharashtra, India
ชื่อแบรนด์
Bioclean
ฟังก์ชัน
เพิ่มอิมัลซิไฟเออร์และการทำให้เป็นไมโครของสารประกอบไฮโดรคาร์บอน
คุณสมบัติ
การเพิ่มตะกอนและการเกิดฟองในถังชีวภาพ
บรรจุภัณฑ์และการนำส่ง
ขายหน่วย
รายการเดียว
เดี่ยวน้ำหนักรวม
1.000 กก.
ระยะเวลารอสินค้า
ตัวเลือกการปรับแต่ง
Customized packaging (ยอดซื้อขั้นต่ำ : 100 แพ็ค )
ดูรายละเอียด
คำอธิบายผลิตภัณฑ์จากซัพพลายเออร์
ปรับแต่งได้
จำนวนสั่งซื้อขั้นต่ำ : 100 แพ็ค
฿484.98
รูปแบบ
เลือกเลยmodel number: -
-
การประมวลผลความจุ
99%
ตัวเลือกการปรับแต่ง
Customized packaging (สั่งซื้อขั้นต่ำ : 100 แพ็ค )
การจัดส่ง
โซลูชันการจัดส่งสำหรับปริมาณที่เลือกไม่มีให้บริการในขณะนี้
การคุ้มครองคำสั่งซื้อ Alibaba.com
การชำระเงินที่ปลอดภัย
ทุกการชำระเงินที่คุณทำบน Alibaba.com มีความปลอดภัยด้วยการเข้ารหัส SSL และโปรโตคอลการป้องกันข้อมูล PCI DSS ที่เข้มงวด
การคุ้มครองการคืนเงิน
รับเงินคืนหากคำสั่งซื้อไม่ถูกจัดส่ง สูญหาย หรือสินค้ามาถึงพร้อมกับปัญหาด้านคุณภาพ












